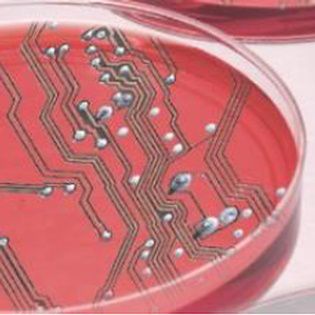
id2-conference

id2 conference. Inter-disciplinary, inter-Doctoral Training Centres
- Dates
- Wednesday 24 June (10:00) - Thursday 25 June 2015 (17:00)
Location: http://id2bham.co.uk/venue-directions/
The id2 conference (inter-disciplinary, inter-DTC) is an exciting opportunity for the nascent community of inter-disciplinary early-career researchers working in the quantitative life sciences, to meet and share their cutting edge research. The conference focuses on PhD candidates and researchers from Doctoral Training Centres encouraging collaborations across different disciplines.
Following successful meetings at UCL (2013) and Oxford (2014), we are delighted to announce that the next conference will be held at the University of Birmingham on the 24th & 25th June 2015. At id2bham you can look forward to:
- Key note talks from world-renowned speakers including Prof Alice Roberts and Prof Gabriel Landini
- Student talks
- Poster sessions
- Development workshops including “Computing for Image Analysis”, “Zeiss Instruments”, and more
- Networking opportunities
- Cash prizes for best posters and presentations
- Social activities
- More information available on the conference website
If your research involves the application of physical science, computational science, maths or engineering to biological problems then we encourage you to submit an abstract and join us in Birmingham!
